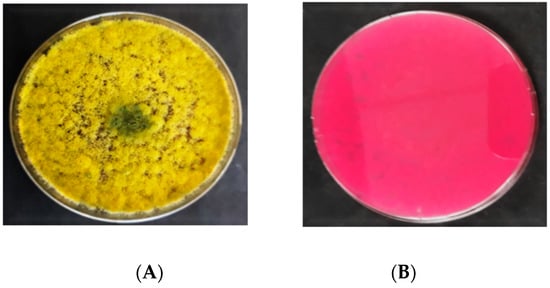
Agriculture 10 00450 g003 550
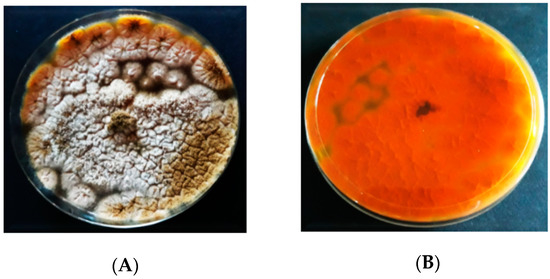
Agriculture 10 00450 g004 550

| Version | Summary | Created by | Modification | Content Size | Created at | Operation |
|---|---|---|---|---|---|---|
| 1 | Rahim Khan | + 1904 word(s) | 1904 | 2021-05-27 06:06:13 | | | |
| 2 | Lindsay Dong | -436 word(s) | 1468 | 2021-06-01 08:03:19 | | |
Video Upload Options
This entry aimed to morphologically characterize and determine the aflatoxigenic and non-aflatoxigenic Aspergillus flavus isolates. Macromorphological characteristics were determined by observing the colony color and texture, while the micromorphological characteristics were determined by examining the spore color, size, structure, conidiophore structure, and vesicle shape. The production of aflatoxin was determined by direct visualization of the UV fluorescence of A. flavus colonies on CCA. Aflatoxin was qualitatively detected in 18 (45%) isolates of A. flavus using UV fluorescence screening while the remaining 22 (55%) isolates did not exhibit any aflatoxin production.
1. Introduction
AFs are extremely potent carcinogens, predominantly found in cereal crops, like corn, rice, nuts, and sorghum [1]. Currently, several AFs have been discovered; however, the most significant AF are AFB1, AFB2, AFG1, and AFG2 [2]. Food contamination with aflatoxigenic Aspergillus spp. and the subsequent production of AF could take place during, pre-and post-harvest stages [3][4][5][6][7]. Food contamination by AFs depends on vulnerability, environmental factors, fungal community, and their capacity to penetrate the food. Humans could be exposed to AF through sporadic intake of adulterated foodstuff, causing nutritional deficiencies, immunosuppression, and hepatocellular carcinoma [8].
Owing to the tropical climate of Malaysia, the temperature remains around 28°C to 31°C [9], and humidity ranges from 60% to 80% [10] throughout the year, which provides a suitable environment for A. flavus to contaminate the food and food products, and produce AF. To the best of our knowledge, no work has been documented thus far on the prevalence of aflatoxigenic and non-aflatoxigenic strains of A. flavus isolated from sweet corn kernels and soil samples collected from the Cameron Highlands region.
2. Morphological Characterization and Determination of Aflatoxigenic and Non-Aflatoxigenic Aspergillus flavus
2.1. Detection of Aspergillus flavus
Forty isolates of A. flavus were detected from the sweet corn and soil samples (Figure 1). The A. flavus isolates were identified through the observation of their morphological characteristics as per the key descriptions by Klich [11] and Clayton [12].

Figure 1. Prevalence of A. flavus isolates in Kampong Raja, Rose Valley, Kea, and Klebang farms; black bars = soil samples; grey bars = maize samples.
2.2. Morphological Characterization of Aspergillus flavus
2.2.1. Macroscopic Characteristics of Aspergillus flavus on PDA
The morphology of A. flavus colonies on PDA is presented in Figure 2. In the beginning, the mycelial color of A. flavus was white. Following 3 d of incubation, the A. flavus colony formed olive-green conidia that dominated the colony’s appearance. Generally, the colonies were flat at their borders while raised in the middle. On PDA, all the A. flavus isolates produced exudates (droplets) that are brown in color or colorless.

Figure 2. Colony morphology of A. flavus on the potato dextrose agar (PDA); (A) = obverse, (B) = reverse.
2.2.2. Macroscopic Characteristics of Aspergillus flavus on DRBC
On DRBC (Figure 3), the A. flavus isolates initially produced white mycelia that were smooth and upraised. Following 3 d of incubation, they produced dark yellow conidia, which transformed into olive green after 6 d. No sclerotia were produced by A. flavus isolates on DRBC. The exudates (liquid droplets) produced were colorless and embedded in the mycelia. The A. flavus isolates did not yield any soluble pigments on DRBC. The reverse sides of A. flavus colonies were colorless. Light purple is the original color of DRBC. The colonies’ diameter of A. flavus ranged from 50 to 70 mm.
Figure 3. Colony morphology of A. flavus on dichloran rose bengal chloramphenicol (DRBC); (A) = obverse, (B) = reverse.
2.2.3. Macroscopic Characteristics of Aspergillus flavus on AFPA
The inoculation of A. flavus on AFPA resulted in the colonies having various profiles and dimensions (Figure 4). The colonies’ color of A. flavus on AFPA was whitish brown with dispersed conidia. On AFPA, the isolates of A. flavus did not produce exudates or soluble pigments. A. flavus produced a bright orange or golden color on the reverse due to the reaction between aspergillic acid with ferric ammonium citrate contained in the medium.
Figure 4. Colony morphology of A. flavus on Aspergillus flavus and parasiticus agar (AFPA); (A) = obverse, (B) = reverse.
2.3. Microscopic Characteristics of Aspergillus flavus
The microscopic characteristics of A. flavus are shown in Figure 5. Under the microscope, the conidiophores of A. flavus isolates were colorless, thick-walled, roughed, and bearing vesicles. The diameter of the conidiophores ranged from 800 to 1200 µm. The vesicle shape of A. flavus isolates was globose to sub-globose. The diameter of the vesicles ranged from 1800 to 2000 µm. The cells were uniseriate or biseriate. In the biseriate cells, the phialides grew on the metulae whereas, in uniseriate cells, they grew on the vesicles. The metulae enclosed the vesicles’ surface and emitted in all directions. The conidia were globose, thin-walled, slightly roughed, and ranged from 250 to 450 µm in diameter.

Figure 5. Microscopic characteristics of A. flavus; (A) = conidiophores and conidia under 10× objective; (B) = conidiophore and conidia under the 100× objective; (C) = conidia under the 100× objective of the stereo–binocular microscope (Magnus M24).
2.4. Screening for Aflatoxin Production
Figure 6 represents the findings obtained from the UV light screening of A. flavus, displaying the fluorescent and non-fluorescent isolates of A. flavus on CCA. It was found that 18 (45%) out of 40 isolates fluoresced blue on CCA once they were exposed to UV light (365 nm), thus indicating the ability of aflatoxin production (Table 1). On the other hand, the remaining 22 (55%) isolates did not exhibit blue fluorescence in UV light, thus classified as non-aflatoxigenic isolates of A. flavus. The distribution of the aflatoxigenic and non-aflatoxigenic isolates of A. flavus in four different farms is presented in Figure 7.

Figure 6. Colonies of the aflatoxigenic and non-aflatoxigenic isolates of A. flavus observed under UV light (365 nm); (A) = aflatoxigenic obverse, (B) = aflatoxigenic reverse, (C) = non-aflatoxigenic obverse, (D) = non-aflatoxigenic reverse.

Figure 7. The distribution of the aflatoxigenic and the non-aflatoxigenic A. flavus isolates in four sweet corn-growing farms in Malaysia. Black bars = number of A. flavus isolates and their respective percentage figure.
3. Conclusions
Overall, the A. flavus had olive-green, yellowish-green, or dark green colonies surrounded by a white circle that was eventually covered by conidia. The colonies’ textures were usually velvety or woolly with a floccose center. The A. flavus colonies produced exudates on two of the four culture media utilized in this study. Similarly, sclerotia were detected in the majority of A. flavus isolates, as it is a specific characteristic of aflatoxigenic A. flavus. In the interpretation of the taxonomic descriptions by Klich [11], the isolates’ colony morphology in this study bore a resemblance to A. flavus as shown in Figure 2 and Figure 3. On the other hand, some other Aspergillus species have the same phenotypical characteristics and which makes it difficult to differentiate them from A. flavus. It is known to have the same colony color as A. oryzae. This renders the need for comprehensive scrutiny using microscopic and macroscopic characteristics for accurate identification and classification. However, there is a consensus that, even microscopically, some characteristics are common among Aspergillus isolates [12]. The microscopic features of A. flavus such as conidiophore, vesicles, sterigmata and conidia were examined in this study.
The screening of A. flavus isolates, based on their fluorescence characteristics under UV light at 365 nm was carried out. Once the aflatoxigenic isolates of A. flavus were exposed to UV light, they showed a blue fluorescence on the reverse of the colonies, while the non-aflatoxigenic A. flavus did not show any fluorescence (Figure 7). Although the culture-based techniques are comparatively simple and economical, for aflatoxin detection, however, these techniques are usually employed in combination with chromatographic methods [13]. For the precise quantification of aflatoxin, a more advanced method such as high-performance liquid chromatography equipped with fluorescence detection (HPLC-FLD) would be useful. Similarly, it has been reported that strains of A. flavus could produce B and G aflatoxins [14], a recent classification of Aspergillus section Flavi noted that such strains, though morphologically similar to A. flavus, were completely novel species [15][16][17]. These outcomes pointed out the fact that modern molecular approaches are mandatory to be used for A. flavus isolates’ characterization.
In conclusion, both aflatoxigenic and non-aflatoxigenic strains of A. flavus were present in the sweet corn kernels and soil of Cameron Highlands, Malaysia. Cameron Highlands being a primary source of agricultural produce could take measures to ensure that aflatoxin contamination is minimized. Non-aflatoxigenic strains indigenously present could be further harnessed into a biological control agent that can reduce the dependency on chemically synthesized pesticides. Culture media and morphology are rapid tools for the characterization of A. flavus. The morphological characteristics of these isolates were similar to those explained in the published identification manuals. The screening of A. flavus isolates for aflatoxin detection under UV light (365 nm) is a fast and reliable method to distinguish the aflatoxigenic and non-aflatoxigenic isolates. Although the culture-based techniques are comparatively simple and economical, however, for the precise quantification of aflatoxin, a more advanced method such as high-performance liquid chromatography equipped with fluorescence detection (HPLC-FLD) would be useful. This further reinforces the need for measures to prevent the fungal contamination of sweet corn and emphasizes the importance of field interventions aimed at curbing agricultural soil contamination by these fungi.
References
- Filazi, A.; Sireli, U.T. Occurrence of aflatoxins in food. In Aflatoxins: Recent Advances and Future Prospects; InTech: Rijeka, Croatia, 2013; pp. 70–143.
- Schmidt-Heydt, M.; Rüfer, C.E.; Abdel-Hadi, A.; Magan, N.; Geisen, R. The production of aflatoxin B1 or G1 by Aspergillus parasiticus at various combinations of temperature and water activity is related to the ratio of aflR, and aflR expression. Mycotoxin Res. 2010, 26, 46–241.
- Alpsoy, L. Inhibitory effect of essential oil on aflatoxin activities. Afr. J. Biotechnol. 2010, 9, 2474–2481.
- Giray, B.; Girgin, G.; Engin, A.B.; Aydın, S.; Sahin, G. Aflatoxin levels in wheat samples consumed in some regions of Turkey. Food Control 2007, 18, 23–29.
- Park, J.W.; Choi, S.Y.; Hwang, H.J.; Kim, Y.B. Fungal mycoflora and mycotoxins in Korean polished rice destined for humans. Int. J. Food Microbiol. 2005, 103, 305–314.
- Reddy, K.R.N.; Reddy, C.S.; Muralidharan, K. Detection of Aspergillus spp. and aflatoxin B1 in rice in India. Food Microbiol. 2009, 26, 27–31.
- Toteja, G.S.; Mukherjee, A.; Diwakar, S.; Singh, P.; Saxena, B.N.; Sinha, K.K.; Sinha, A.K.; Kumar, N.; Nagaraja, K.V.; Bai, G.; et al. Aflatoxin B1 contamination of parboiled rice samples collected from different states of India: A multi-center study. Food Addit. Contam. 2006, 23, 411–414.
- Wagacha, J.M.; Muthomi, J.W. Mycotoxin problem in Africa: Current status, implications to food safety and health and possible management strategies. Int. J. Food Microbiol. 2008, 124, 1–12.
- Abdullah, N.; Nawawi, A.; Othman, I. Survey of fungal counts and natural occurrence of aflatoxins in Malaysian starch-based foods. Mycopathologia 1998, 143, 53–58.
- Sulaiman, M.R.; Yee, C.F.; Hamid, A.; Yatim, A.M. The occurrence of aflatoxins in raw shelled peanut samples from three districts of Perak, Malaysia. Electron. J. Environ. Agric. Food Chem. 2007, 6, 2045–2052.
- Klich, M.A. Identification of Common Aspergillus Species; Centraalbureau voor Schimmelcultures (CBS) Fungal Biodiversity Centre, Royal Netherlands Academy of Arts and Sciences: Utrecht, The Netherlands, 2002; pp. 426–432.
- Clayton, Y.M. Medically Important Fungi: A Guide to Identification. Proc. R. Soc. Med. 1977, 70, 359.
- Cotty, P.J.; Jaime-Garcia, R. Influences of climate on aflatoxin producing fungi and aflatoxin contamination. Int. J. Food Microbiol. 2007, 119, 109–115.
- Abbas, H.K.; Zablotowicz, R.M.; Weaver, M.A.; Horn, B.W.; Xie, W.; Shier, W.T. Cultural methods for aflatoxin detection. J. Toxicol. Toxin Rev. 2004, 23, 295–315.
- Takahashi, H.; Kamimura, H.; Ichinoe, M. Distribution of aflatoxin-producing Aspergillus flavus and Aspergillus parasiticus in sugarcane fields in the southernmost islands of Japan. J. Food Prot. 2004, 67, 90–95.
- Pildain, M.B.; Frisvad, J.C.; Vaamonde, G.; Cabral, D.; Varga, J.; Samson, R.A. Two novel aflatoxin-producing Aspergillus species from Argentinean peanuts. Int. J. Syst. Evol. Microbiol. 2008, 58, 35–725.
- Varga, J.; Frisvad, J.C.; Samson, R.A. Two new aflatoxin producing species, and an overview of Aspergillus section Flavi. Stud. Mycol. 2011, 69, 57–80.





